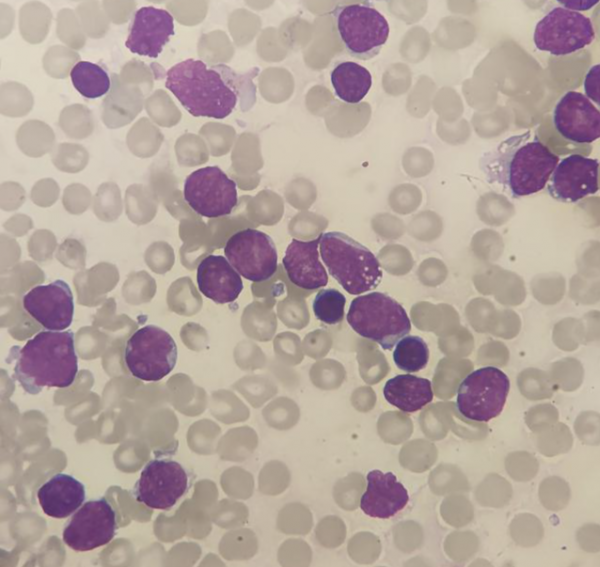
病例分享丨一例慢性髓系白血病急淋變的診斷過程

單位 | 河南大學淮河醫院檢驗科
慢性髓系白血病(CML)是骨髓造血幹細胞克隆性增殖形成的惡性腫瘤。其自然病程分為慢性期、加速期、急變期。酪氨酸激酶抑制劑(TKI)作為治療CML的靶向藥物能阻止疾病的進展,延長患者的生存期,給多數患者帶來新生。
然而,還是有部分患者由於各種原因而進展到急變期。CML可急變為各種型別的急性白血病,以急粒變最常見,約佔50%-60%,其次為急淋變,約佔20%-30%[1]。今天為大家分享一例CML急淋變的病例。
案例經過
患者,男性,43歲,2019年6月以“乏力1年餘,發現白細胞升高5天”為主訴入院。1年前患者無明顯誘因出現乏力,未在意,未治療,5天前體檢時查血常規:白細胞314.13×109/L,紅細胞3.42×109/L,血紅蛋白102g/L,血小板823×109/L。
腹部彩超提示脾臟腫大。近1年來體重減輕5Kg。既往體健。入院查體:T37.2℃,P100次/分,R20次/分,Bp139/90mmHg。面板未見出血點、無黃染。全身淺表淋巴結未觸及腫大,肝、脾肋緣下未觸及。入院後完善了相關檢查:
血常規原始結果:
結合患者病史及初步檢查:外周血白細胞明顯增高,以中性粒細胞增高為主,伴有嗜酸和嗜鹼的增高,肝脾腫大,首先應考慮骨髓增殖性腫瘤中的CML,當然患者血小板也高,所以原發性血小板增多症(ET)也不能排除。需完善白血病相關檢查綜合診斷。
骨髓細胞學:

根據骨髓形態、流式、染色體、融合基因綜合診斷為CML(慢性期)。
之後患者僅在2019.7因肛周疼痛再次入院治療,好轉出院以後未再來醫院定期就診。直到2021年9月患者以“診斷CML 2年,牙齦腫痛1周”為主訴再次入院。完善相關檢查。
血常規:行外周血塗片分類原始細胞佔95%,考慮CML急變。
急診生化:
我們先複習一下CML的診斷分期標準[2]
1.診斷標準:典型的臨床表現,合併Ph染色體和(或)BCR-ABL融合基因陽性即可確定診斷。
2.CML的分期
(1)慢性期:①外周血或骨髓中原始細胞<10%;②未達到診斷加速期或急變期的標準。
(2)加速期:符合下列任何一項:①外周血或骨髓中原始細胞佔10%-19%;②外周血嗜鹼性粒細胞≥20%;③對治療無反應或非治療引起的持續血小板減少(PLT<100×109/L)或增高(PLT>1000×109/L);④治療過程中出現Ph陽性細胞基礎上的其他克隆性染色體異常;⑤進行性脾臟增大或WBC增高。
(3)急變期:①外周血或骨髓中原始細胞≥20%;②骨髓活檢原始細胞集聚;③髓外原始細胞浸潤。
那CML急變的機制是什麼呢?查閱文獻[3]得知:CML急變的具體機制尚不完全明確,多數認為是一個多因素參與的過程,其中基因突變和染色體畸變是導致CML急變的最主要原因。
其中最主要的是染色體的增加、基因的缺失、插入和點突變等,以及P53的缺失、突變等。TKI治療耐藥中也存在重要的基因突變,BCR-ABL激酶區的TKI耐藥性突變起主導作用,突變後CML細胞的集落形成能力、增殖能力、激酶活性以及底物的利用能力都會增強,由此更易導致CML的進展。
急變後Ph染色體既會影響髓系幹細胞,也影響淋系幹細胞。因此CML可以急髓變和急淋變。那麼此患者發生急淋變的可能原因又有哪些呢?
回顧了這個患者在首次入院期間所查血常規中白細胞數和嗜鹼性粒細胞百分比變化趨勢,如下圖。
發現其白細胞數隨著治療後明顯減低,但嗜鹼粒細胞百分比卻明顯增高,最高達30.7%。符合了加速期的診斷標準之一,這點可能是患者急變的原因之一。
另外患者在急淋變後檢查的BCR-ABL定量陰性和基因耐藥突變陰性也說明了患者並不是由於TKI治療反應差和耐藥的原因導致的急變。不過患者出現了Ph染色體伴額外Ph染色體以及TET2突變基因,而染色體畸變和基因突變正是CML急變最主要的原因,因此患者這兩項指標的異常也許是急淋變發生的真正原因。
CML的額外染色體異常型別,常見的為+8(佔額外異常的34%),+Ph(30%),i(17q)(25%),+19(13%),﹣Y(8%),+21(7%),+17(5%),單體7(5%),急髓變常發生i(17q)以及P53突變,急淋變常出現單體7及亞二倍體。不論急淋變或急髓變患者,只要伴有雙Ph、亞二倍體,患者發病迅速、進展快、治療效果差[4]。
對於急變期的治療,應參照患者既往治療史、基礎疾病以及突變情況選擇TKI單藥或聯合化療提高誘導緩解率,緩解後應儘快行異基因造血幹細胞移植(Allo-HSCT)[2]。
參考文獻
[1]劉亞琳,王曉寧,劉華勝.慢性粒細胞白血病急粒變與急淋變骨髓細胞形態學、免疫表型、細胞遺傳學特徵及預後差異分析[J].中國實驗血液學雜誌,2014,22(03):629-633.
[2]慢性髓性白血病中國診斷與治療指南(2020年版)[J].中華血液學雜誌,2020(05):E001-E001.
[3]楊肖肖,楊巖,馬洪波.慢性髓系白血病急淋變繼而急髓變1例[J].中國實驗診斷學,2019,23(07):1216-1218.
[4]孫川,李倩,林穎等.慢性粒細胞白血病額外染色體異常在加速期和急變期的意義[J].醫學研究雜誌,2014,43(01):108-110.